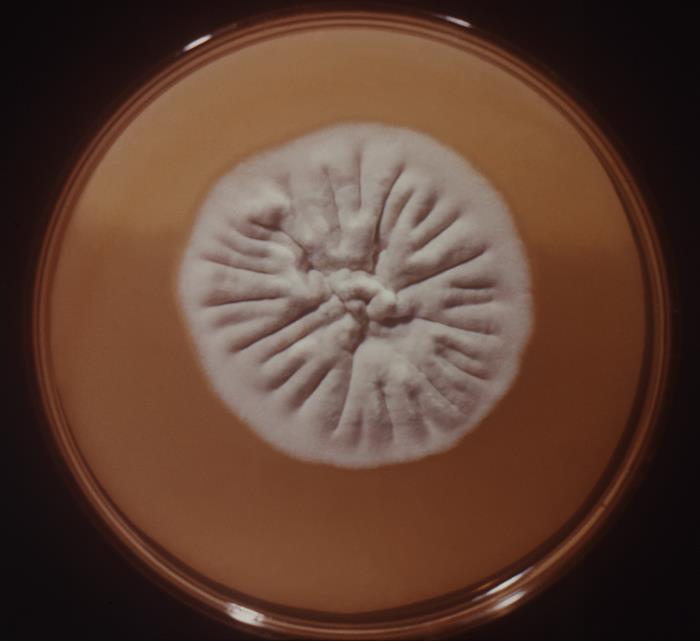

Trichophyton rubrum es un hongo filamentoso perteneciente al filo Ascomycota, antropofílico.
Microscópicamente tiene hifas largas y delgadas, los microconidios son abundantes con forma piriforme a redondeada, raramente hay macroconidios con pared delgada, multiseptados, de tamaño variable y con forma de puro o cigarrillo (3).
Macroscópicamente las colonias son algodonosas, con el tiempo toman un aspecto aterciopelado y pulverulento, de color blanquecino a amarillento o rojo violeta. El reverso de la colonia suele tener un color rosado-rojo, pero, en ocasiones, puede ser amarillo-marrón, rojo-vino o violeta e, incluso, pueden carecer de pigmento (3).
Viabilidad, propagación y transmisión
Reservorio
Humanos, suelo y fómites.
Hospedadores
Humanos.
Dosis Infectiva Mínima (DIM)
Se desconoce en la actualidad.
Supervivencia ambiental
Sobreviven bien en lugares cálidos y húmedos. Las esporas pueden sobrevivir en distintas superficies, en la ropa, en el suelo, en el agua dulce y salada y, durante meses, en escamas de la piel a temperatura ambiente.
Formas de resistencia
Esporas.
Mecanismo de propagación y transmisión
La transmisión se produce principalmente por el contacto directo o indirecto. Contacto con la piel o con las lesiones de un individuo afectado, así como con fómites como utensilios o herramientas contaminados con pelos o escamas como: gorros, ropa, cepillos o peines, etc.
Las esporas se pueden transportar por el aire y contaminar distintas zonas cercanas.
También se podrían dar casos de sensibilización o alergia por inhalación de las esporas del hongo, en operaciones que impliquen la generación de bioaerosoles a partir de material o especímenes colonizados por el hongo (2) (4) (12).
Vías de entrada
Dérmica. Respiratoria (para efectos alérgicos).
Distribución geográfica
Mundial.
Efectos sobre la salud
Grupo de riesgo
2 A
(Ver Anexo II RD 664/1997 )Infección
Dermatofitosis o tiñas: micosis superficiales que pueden afectar a la piel y faneras (pelo, uñas) de distintas partes del cuerpo, recibiendo distintos nombres en función de la zona afectada: tinea corporis, tinea cruris, tinea capitis (pelo), tinea pedis o pie de atleta, tinea manuum o de la mano y tinea unguium u onicomicosis (uña). Las manifestaciones clínicas son lesiones eccematosas, a veces, formación de vesículas y pústulas, intertrigo, decoloración de las uñas.
Efectos alérgicos (Ver Anexo II RD 664/1997 ) / (Ver Allergen )
En las últimas dos décadas se ha establecido un vínculo definitivo entre la sensibilización a Trichophyton y la alergia. La presencia del hongo y sus productos metabólicos normalmente induce una respuesta alérgica e inflamación eccematosa en el huésped. Existe bastante evidencia que respalda el vínculo entre la dermatofitosis y las enfermedades alérgicas como el asma, la urticaria, la rinitis y la dermatitis atópica (2) (4) (12).
Efectos tóxicos (Ver Anexo II RD 664/1997 )
No se han descrito
Efectos cancerígenos (Ver International Agency for Research On Cancer - IARC )
No se han descrito
Efectos en la maternidad
No se han descrito
Enfermedad
| CIE-10 | Nombre | Enfermedad de Declaración Obligatoria |
|---|---|---|
| B35 | Dermatofitosis | No |
Actividades laborales con riesgo
Clasificación Nacional de Actividades Económicas (CNAE)
| CNAE 2009 | Descripción |
|---|---|
| N7210 | Investigación y desarrollo experimental en ciencias naturales y técnicas |
| P8424 | Orden público y seguridad |
| P8425 | Servicios de extinción de incendios |
| Q8510 | Educación preprimaria |
| Q8520 | Educación primaria |
| Q8551 | Educación deportiva y recreativa |
| R8610 | Actividades hospitalarias |
| R8621 | Actividades de medicina general y de medicina familiar y comunitaria |
| R8622 | Actividades de otras especialidades médicas |
| R8699 | Otras actividades sanitarias n.c.o.p. |
| R8710 | Asistencia en establecimientos residenciales con cuidados sanitarios |
| R8720 | Asistencia en establecimientos residenciales para personas que padecen una enfermedad mental o una drogodependencia o que han recibido un diagnóstico al respecto |
| R8731 | Asistencia en establecimientos residenciales para personas mayores |
| R8732 | Asistencia en establecimientos residenciales para personas con discapacidad física |
| R8811 | Actividades de servicios sociales sin alojamiento para personas mayores |
| R8812 | Actividades de servicios sociales sin alojamiento para personas con discapacidad |
| R8891 | Actividades de cuidado diurno de niños |
| T9610 | Lavado y limpieza de prendas de tela y de piel |
| T9621 | Peluquerías y barberías |
| T9630 | Pompas fúnebres y actividades relacionadas |
Clasificación Nacional de Ocupaciones (CNO)
| CNO 2011 | Descripción |
|---|---|
| 2111 | Médicos de familia |
| 2112 | Otros médicos especialistas |
| 2122 | Enfermeros especializados (excepto matronos) |
| 2152 | Fisioterapeutas |
| 2157 | Podólogos |
| 2240 | Profesores de enseñanza primaria |
| 2251 | Maestros de educación infantil |
| 2252 | Técnicos en educación infantil |
| 2311 | Profesores de educación especial |
| 2312 | Técnicos educadores de educación especial |
| 2421 | Biólogos, botánicos, zoólogos y afines |
| 3314 | Técnicos en laboratorio de diagnóstico clínico |
| 3331 | Profesionales de la acupuntura, la naturopatía, la homeopatía, la medicina tradicional china y la ayurveda |
| 3723 | Instructores de actividades deportivas |
| 3724 | Monitores de actividades recreativas y de entretenimiento |
| 5611 | Auxiliares de enfermería hospitalaria |
| 5612 | Auxiliares de enfermería de atención primaria |
| 5622 | Técnicos de emergencias sanitarias |
| 5629 | Trabajadores de los cuidados a las personas en servicios de salud no clasificados bajo otros epígrafes |
| 5710 | Trabajadores de los cuidados personales a domicilio |
| 5721 | Cuidadores de niños en guarderías y centros educativos |
| 5722 | Cuidadores de niños en domicilios |
| 5811 | Peluqueros |
| 5812 | Especialistas en tratamientos de estética, bienestar y afines |
| 5891 | Asistentes personales o personas de compañía |
| 5892 | Empleados de pompas fúnebres y embalsamadores |
| 5992 | Bañistas-socorristas |
| 9210 | Personal de limpieza de oficinas, hoteles y otros establecimientos similares |
Prevención y control
Desinfectantes
Cloruro de benzalconio, compuestos fenólicos, formaldehido, glutaraldehído, yodóforos e hipoclorito sódico al 1% (11).
Inactivación física
Se inactiva con radiación ultravioleta C, microondas y con calor húmedo a 121ºC durante al menos 20 minutos, y con calor seco a 170ºC durante al menos 2 horas.
Antimicrobianos
Griseofulvina, ketoconazol, itraconazol, fluconazol, terbinafina, voriconazol, clotrimazol, etc. (9).
Vacunación
No disponible
Medidas preventivas generales
Evitar el contacto con personas afectadas y con material que haya estado en contacto dérmico con las mismas.
Evitar el exceso de humedad y temperatura en los locales de trabajo.
Evitar la generación de aerosoles.
Orden y limpieza en el lugar de trabajo (la limpieza preferiblemente con métodos de aspirado para eliminar escamas y pelos). Desinfección de instalaciones, equipos y materiales.
Higiene personal, mantener la piel limpia y seca, especialmente en las zonas de los pliegues, lavado de manos después de tocar materiales o elementos potencialmente contaminados.
Utilizar ropa de trabajo que permita la transpiración y evite la sudoración excesiva. Cambiarse la ropa o el calzado mojado o húmedo. No compartir objetos personales, toallas, calzado, equipos de protección individual (guantes).
Precauciones en centros sanitarios
EPI
Protección de las manos: guantes impermeables para manipular especímenes, pacientes o materiales que puedan estar contaminados.
Protección respiratoria: mascarillas autofiltrantes tipo FFP2, preferiblemente FFP3 para operaciones en las que se generen gran cantidad de bioaerosoles.
Protección ocular o facial: gafa de protección de montura universal en caso de riesgo de contacto accidental mano/guante contaminado-ojo, o pantalla de protección facial (símbolo de marcado en montura: 3) en caso de riesgo de exposición a salpicaduras, o gafa de protección de montura integral con hermeticidad frente a partículas (símbolo de marcado en montura: 4), en caso de riesgo de exposición a polvo.
Seguridad en laboratorio
Nivel de contención: 2
Los principales riesgos son la exposición de la piel al manipular cultivos del agente, muestras o materiales contaminados.
Las muestras o especímenes más peligrosos son tejidos queratinizados (piel, pelo, uñas) de pacientes afectados, muestras del suelo contaminadas o útiles contaminados.
Se requieren las prácticas y la contención de un nivel 2 de bioseguridad, evitar el empleo de material cortante o punzante, utilizar cabina de seguridad biológica en aquellas operaciones que impliquen la generación de bioaerosoles, proyecciones o salpicaduras y utilizar guantes impermeables en el caso de contacto con muestras contaminadas y bata o ropa de trabajo.
Bibliografía
- Acha, P. N., & Szyfres, B. (2001). Zoonosis y enfermedades transmisibles comunes al hombre y a los animales (3ª ed.): Volumen I. Bacteriosis y micosis. Organización Panamericana de la Salud.
- Alonso, A., Pionetti, C. H., Mouchián, K., Albónico, J. F., Irañeta, S. G., Potenza, M., & Iovannitti, C. (2003). Hipersensibilidad a los antígenos del Trichophyton rubrum en podólogos atópicos y no atópicos. Allergologia et immunopathologia, 31(2), 70-76.
- Pontón, J., Moragues, M. D., Gené, J., Guarro, J., & Quindós, G. (2002). Hongos y actinomicetos alergénicos. Revista Iberoamericana de Micología.
- Woodfolk, J. A. (2005). Allergy and dermatophytes. Clinical microbiology reviews, 18(1), 30-43. DOI: 10.1128/CMR.18.1.30-43.2005.
- Centers for Disease Control and Prevention (CDC). (2019). Guideline for isolation precautions: preventing transmission of infectious agents in healthcare settings. CDC: Infection control.
- Comisión de Salud Pública del Consejo Interterritorial del Sistema Nacional de Salud. Ministerio de Sanidad y Consumo. (2001). Protocolo de vigilancia sanitaria específica para los/as trabajadores/as expuestos a agentes biológicos.
- Institut National de Recherche et de Sécurité (INRS). (2023). Trichophyton rubrum. BAse d'OBservation des Agents Biologiques (BAOBAB).
- Instituto Nacional de Seguridad y Salud en el Trabajo (INSST). Notas Técnicas de Prevención (NTP): 539, 689, 700, 822, 858 y 938.
- Public Health Agency of Canada. (2011).Epìdermophyton floccosum, Microsporum spp., Trichophyton spp. Pathogen Safety Data Sheets.
- Servicio Riojano de Salud. (2008). Precauciones de aislamiento en centros sanitarios.
- The Center for Food Security and Public Health (CFSPH). (2013). Dermatophytosis. CFSPH: Disease information.
- Thermo Fisher Scientific. (2022). Trichophyton rubrum. Allergy & autoinmune disease: Allergen encyclopedia.